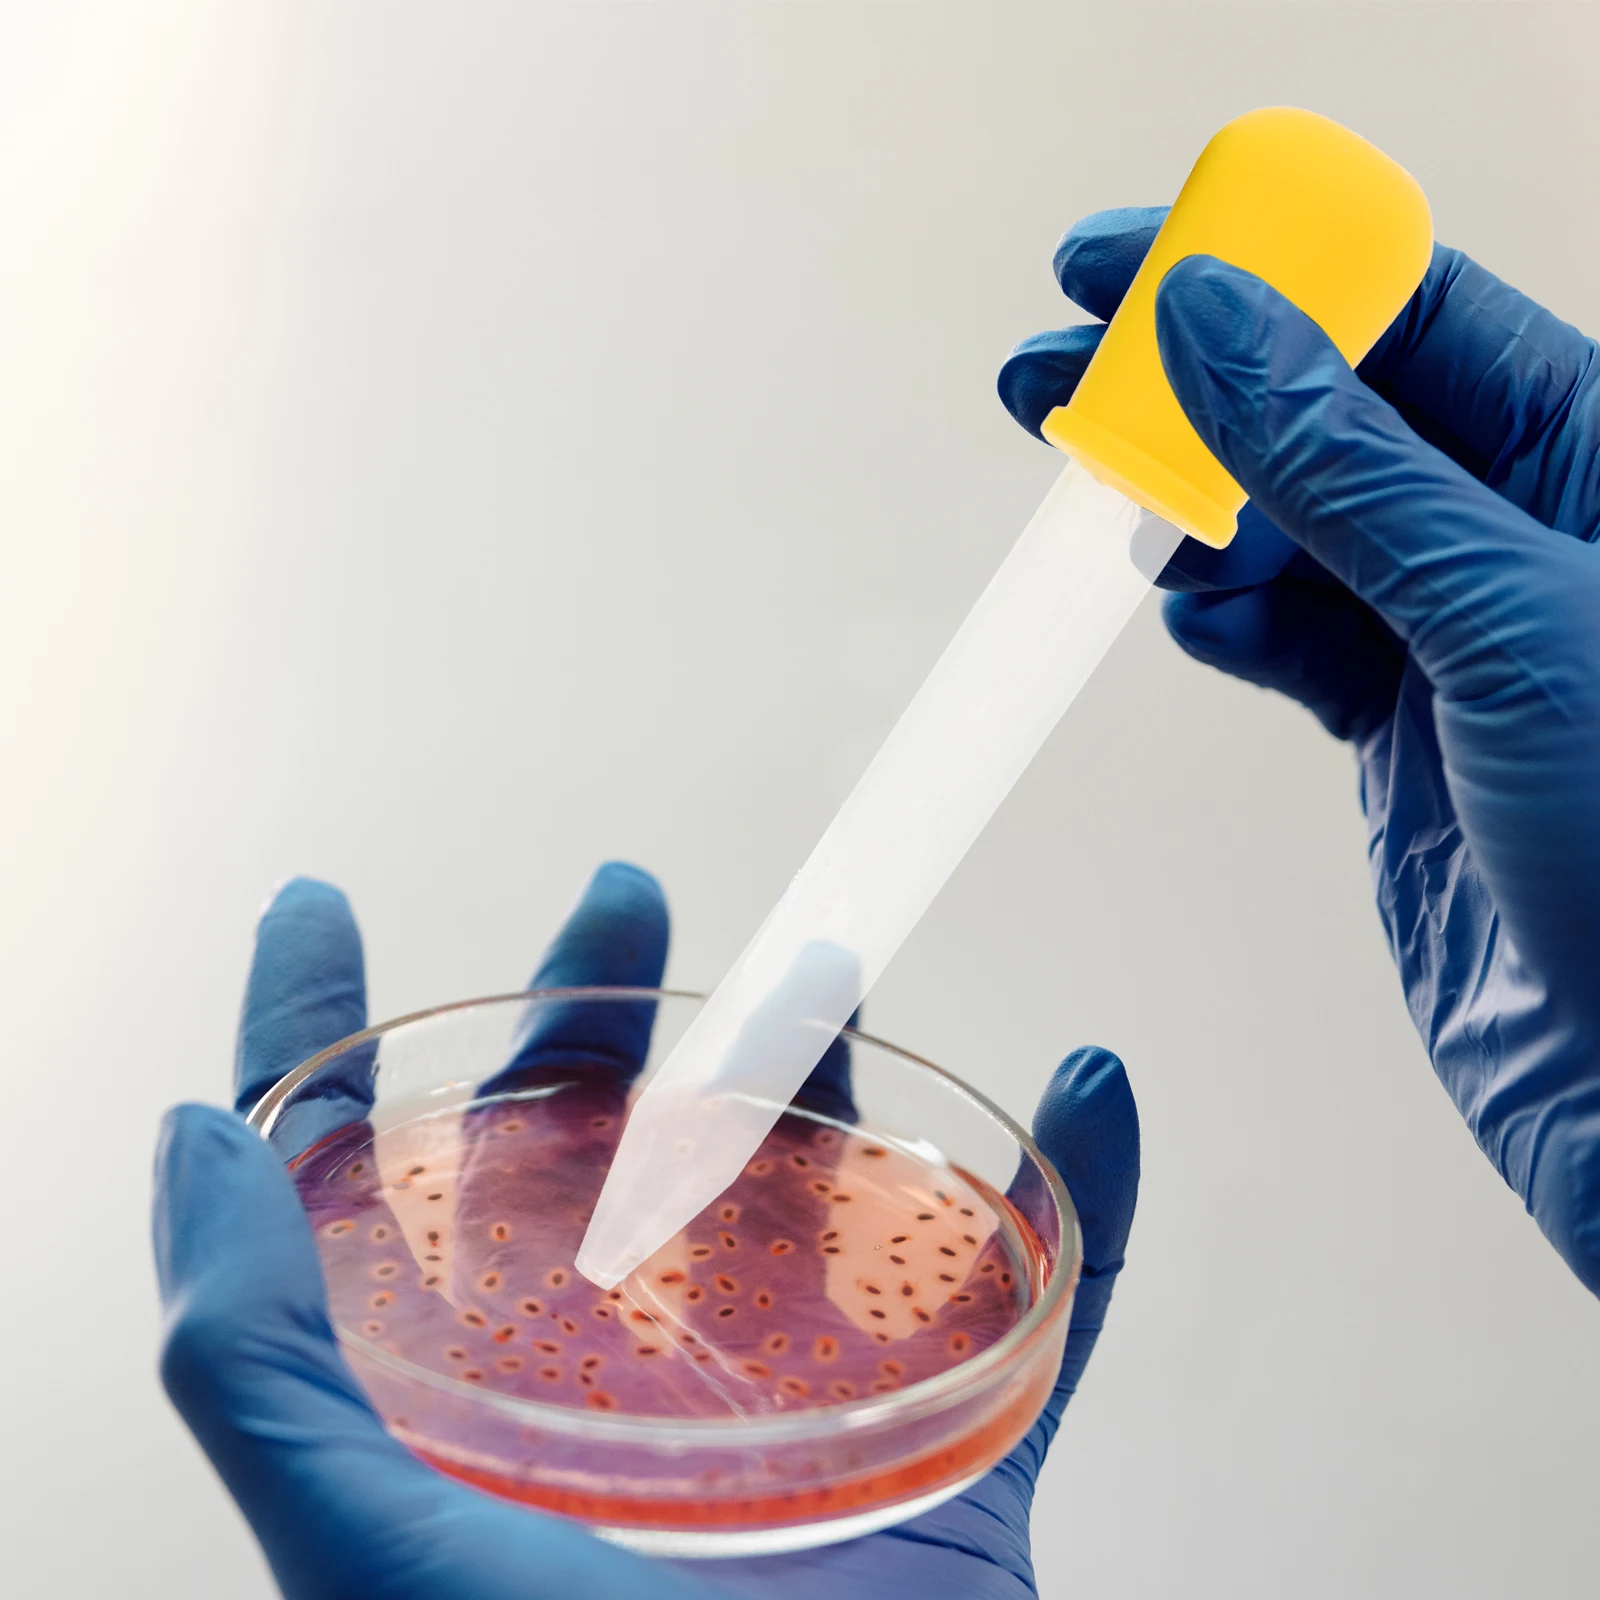

22107930 23126245 Hand Brake Button Parking Brake Switch Hand Brake Control Switch Auto For Volvo FH FM EURO6 Truck
График изменения цены & курс обмена валют
Пользователи также просматривали

$4.34
Motorcycle Handlebar Grips Handle Throttle Turn Grip grip end For Gilera NEXUS500 NEXUS nexus 500 2004~2025 2024 2023 2022 2021
aliexpress.ru
$4.37
7/8'' Motorcycle Handlebar Grip Throttle Hand Bar Grips For BMW F750GS F800GS F850GS R1200GS R1250GS ADVENTURE R R1250 GS ADV
aliexpress.ru
$34.81
Watercolor Ink Blooming Gel Nail Polish 9 Colors Smoke Effect Blossom Gel Varnishes for Manicure Nail Art Gel Lacquer 7ml
aliexpress.ru
$49.79
Профессиональный интеллектуальный перезаряжаемый автоматический умный беспроводной беспроводной робот-пылесос для влажной и сухой уборки
aliexpress.ru
$376.45
Прочные планшеты Blackview Active 10 Pro 5G, 11-дюймовый дисплей FHD+, 12 ГБ, 256 ГБ/512 ГБ, Android 14, аккумулятор 30000 мАч, камера 108 МП, MTK 7300
aliexpress.ru
$1,554.16
ECR350PE Лучшая цена Резак для пластиковых труб Резак для полиэтиленовых труб Резак для труб из ПВХ 160-350 мм
aliexpress.ru
$19.81
Газовый паяльник NOCM, тепловая пушка, нагнетательная горелка, самовосплатный мгновенный запуск, регулируемый контроль пламени, сварочный инструмент D
aliexpress.ru
$1.07
6pcs Silicone Dropper Clear Liquid Dispenser Non-Breakable Feeding Tube Detachable Rubber Scale Marked for Oil Milk Juice Eye
aliexpress.ru
$1.80
1 Set 3V6V Dc Gear Motor High Torque Diy Robot Components Plastic Material Long Service Life Electric Toys Parts
aliexpress.ru
$2.01
2Pcs Snare Strap Belt Adjustable Length Comfortable Design Military Sling Snare Drum Strap Nylon Material Replacement
aliexpress.ru
$9.32
Sexy Deep V-Neck T-Shirt For Women With Short Design, Tied Straps, Waist Cinching, Slimming Effect, Versatile Base Shirt, Temper
aliexpress.ru
$24.69
3561Classic Boy Denim Jacket Youth Denim Coat Jacket Spring Autumn Fashionable Boy Jacket Children's Denim Shirt Jacket
aliexpress.com
$8.23
Черный а Φ фонарь для сварки Tig, с гибкой головкой, с газовым охлаждением, 26 серии
aliexpress.ru
$19.43
Лидер продаж, детская одежда, зимняя бархатная теплая толстовка с капюшоном, пуловер и брюки, костюм из 2 шт./компл., спортивная одежда, свитер, новый спортивный костюм
aliexpress.ru
$18.90
Спортивные штаны для шарнирных кукол в масштабе 1/4, 1/3, аксессуары для одежды, аксессуары для шарнирных кукол аксессуары для кукол SD, в комплект не входят кукла, обувь, парик и другие E2410
aliexpress.ru
$16.19
Ошейник для объектива Sony FE 200-600 F5.6-6.3 G OSS, кольцо для крепления штатива
aliexpress.ru
$19.48
Swimsuit Women One Piece Swimming Suit Letters Fashion Swimsuit Bandage One-Piece Suits Thong Backless Bathing Suit Monokini
aliexpress.com
$1.13
24pcs False Nail Tips Cartoon Cute Animals Patterns Cat Pink Short Fake Nails Art Women Children Acrylic Nail Makeup Tips
aliexpress.com
$1.09
Pregnant Women Underwear Breastfeeding Cotton Maternity Bra Wirefree Front Buckle Widen Shoulder Strap Cotton Nursing Bra
aliexpress.com
$122.00
Used Graphics Cards XFX R9 380 4GB GDDR5 256bit PCI-E 3.0 HDMI DisplayPort DVI-D 1792SPs Desktop Game graphic cards
aliexpress.com
$4.99
PipiFren Folding Travel Bags hand Luggage Packing Cubes Weekend big pink bag Nylon For women and men large bag bolsa de viaje
aliexpress.com
$29.28
GALCAUR Summer Striped Dress For Women Off Shoulder Sleeveless Bowknot Oversized Midi Dresses Female Fashion 2019 Casual New
aliexpress.com
$2.90
1100pcs/lot Black Mix Sizes Ceramic Beads Half Round Flatback Pearl 2mm 3mm 4mm 5mm 6mm 8mm mixed for DIY Glue Nail Art Garments
aliexpress.com
$15.19
Wedding Candlestick Cosmetics Receptacle Handicraft Sign Penholder Decorative Props
aliexpress.com
$12.60
0-4mm 0.01mm indicator Setter clock accessory for CNC Router Z Axis Zero accessory Pre-setter Tool
aliexpress.com
$7.02
Maillot de Bain Femme 2018 Sexy One Piece Swimsuit Women Green Leaves & Floral Swimwear High Cut Bandage Swim Wear Bathing Suits
aliexpress.com
$14.44
Motorcycle High Quality Outer Rim Wheel Decal Reflective Stickers For BMW C650 Sport Stickers
aliexpress.com
$24.95
ZALAVOR Plus Size 32-46 Women High Heels Ankle Boots Winter Snake Print Sexy Pointed Toe Shoes Women Casual Office Footwear
aliexpress.com$3.87
MKS 3D relief fish crane fortune cat maneki neko wealth and health soft silicon case For Xiaomi black shark Mi Note3 5X Mi A1
aliexpress.com
$0.55
15pcs 86*60cm Bing Bunny Foil Balloon Cartoon Rabbit Balloons 12inch red black Dot Latex Balloon Birthday Party Decor Supplies
aliexpress.com
$2.26
Fashion Lovely Cute Multicolor Keychain Fur pompon Rainbow keyring Women Bag pendant Key chains custom keychain
aliexpress.com
$3.77
Cartoon Frozen Wall Sticker Pvc Wall Stickers Wall Art for Living Room Company School Office Decoration Home Party Wallpaper
aliexpress.com
$20.24
YAOPEI 5WS40039 ,55PP02-03 NEW Fuel Pressure Sensor For Ford Focus C-Max S-MAX Galaxy Mondeo Transit Tourneo 1.8 TDCi
aliexpress.com
$7.42
YOJULY Movie Kill Bill Uma Thurman 3D Printed T-shirt Unisex Fashion Casual Sweatshirt Men Women Vest/t shirt/zipper hoodie K57
aliexpress.com
$4.73
Rainbow cz safety pin earring 2019 small design jewelry for women lady gift Gold filled rainbow 925 silver earring for women
aliexpress.com
$2.21
High Quality Copper Fatima Hand CZ Jewelry Components Micro Pave Cubic Zirconia Evil Eye DIY Jewelry Accessories
aliexpress.com
$63.48
Sexy Gold Stones Nude Jumpsuits Big Stretch Rhinestones Bodysuit Nightclub Women Dance Show Prom Party Sexy One-piece Stage Wear
aliexpress.com
$13.60
Suede Women Handbag Female 2019 Autumn New Fashion Messenger Bag Brand Chain Shoulder Bag Retro Small Square Crossbody Bag
aliexpress.com$1.50
REWOOD DIY Wood Character Painting Kit Set Cinnamoroll Kuda | 12,5cm | Mainan Melukis Mewarnai
shopee.co.id
$2.08
Rurihai Vollkleber Temperierter Glasschilddrüter Vollbedeckung Für Samsung Galaxy S20 fe 4g/fe 5G/S20 Lite/S20 fe 2022, Galaxy S20 FE
tvc-mall.com
$55.23
12 Pcs VER012 MAX PCI-E Riser Card PCI-E 1X to 16X Graphics Riser Card with 10 Solid Capacitors/LED Light for BTC Mining
aliexpress.com
$19.27
Новинка Осень-зима, модное однотонное кожаное пальто с длинным рукавом и коротким меховым воротником, вязаный кардиган с пушистым воротник...
aliexpress.ru
$5.30
Накидки для купальников, женский купальник 4x, бикини, купальник из 2 предметов, купальник на бретельках с открытой спиной и вырезами, купальн...
aliexpress.com



